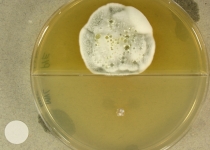

Search Details
| UAMH Number: | 10958 |
|---|---|
| Species Name: | Pseudogymnoascus destructans |
| Type: | paratype Geomyces destructans |
| Synonyms: | Geomyces destructans |
| Taxonomy: | FUNGI Ascomycota, Leotiomycetes, Thelebolales, Pseudeurotiaceae |
| Strain History: | Blehert, D. (22004-1) -> UAMH |
| Substrate: | wing (I1), little brown bat (Myotis lucifugus) | Location: | USA Connecticut, Litchfield County (GEO: 41.787,-73.277) |
| Isolator: | |
| Isolation Date: | |
| Date Received: | 2008-11-14 |
| Characters: | CYCLOHEXIMIDE sensitive (no growth MYC) - // HUMAN/ ANIMAL PATHOGEN associated with bat white-nose syndrome - Blehert DS, Hicks AC, Behr M, Meteyer CU, et al, Sciencexpress online 30 October 2008; 10.1123/science.1163874 // HUMAN/ ANIMAL PATHOGEN associated with bat white-nose syndrome - Gargas A, Trest MT, Christensen M, Volk TJ, Blehert DS, Mycotaxon 108:147-154, 2009 // PSYCHROPHILIC optimum 9C; poor growth at 18C - (Click for publications citing UAMH 10958) |
| Compounds: | |
| Cross Reference: | |
| Collections: | Living Strains; Dried Herbarium Material |
| Pathogenic Potential: | Human: no | Animal: yes | Plant: no |
| Biosafety Risk Group: | RG2 (check the PHAC ePATHogen Risk Group Database for updates) |
| Regulatory Requirements: | Canadian requesters must provide PHAC Pathogen and Toxin License Number (see: https://www.canada.ca/en/public-health/services/laboratory-biosafety-biosecurity/licensing-program.html) and a CFIA Written Authorization for transfer (http://www.inspection.gc.ca/plants/plant-pests-invasive-species/directives/date/d-12-03/eng/1432656209220/1432751554580#app2) prior to shipment. International requesters must provide all legally required importation documentation prior to shipment. This strain is not available for shipment to Cuba, the Democratic People's Republic of Korea, Iran or Syria. Plant pathogenicity status may be verified by using the USDA Agricultural Research Service (ARS) Fungal Database |
| MycoBank ID: | 804767 |
| Sequences: | >UAMH10958_EU884924_SSU AGCACGACTGTAAATAAGTCTCCCTTCATGCAAGTCAGCACCCGCTGGCAACACGATCGAATTGACGGGGACGTCCTAAAGCCTACAACACCAACCCGCCCGGGAAACCGAGGCGGGGGCCCGTGCTAACTCCACGGGGTGGTAAAAGAGTGTATGGATACTCCCTCTGGGGAACTATGGATAATCCGCAGCGAAGACCCTAAGTAGCGCTAGCTATACGGGTAACGTTCACAGACTAAGTGGTTGTGGGTGGAGCCTAGCTCTGCTTAAGATATAGTCGGGCCCTACGTGAAAGCGCAGGGGTGAGTCGCTACGAACTCGAAACCGTTCCGTAGGTGAACCTGCGGAAGGATCATTACAGTAGTCGCCCGGGTTGCCGCAAGGCCTCCCGGGTAACCTACCACCCTTTGTTTATTACACTTTGTTGCTTTGGCAGGCCTGCCCTCGGGCTGCTGGCTCCGGCCGGCGAGCGCTTGCCAGAGGACTAAACTCTGTTTGTCTATACTGTCTGAGTACTATATAATAGTTAAAACTTTCAACAACGGATCTCTTGGTTCTGGCATCGATGAAGAACGCAGCGAAATGCGATAAGTAATGTGAATTGCAGAATTCAGTGAATCATCGAATCTTTGAACGCACATTGCGCCCCCTGGTATTCCGGGGGGCATGCCTGTCCGAGCGTCATTACAACCCTCAAGCTCAGCTTGGTATTGGGCCCCGCCGACCCGGCGGGCCCTAAAGTCAGTGGCGGTGCCGTCCGGCTCCGAGCGTAGTAATTCTTCTCGCT >UAMH10958_FJ231093_SSU TGGTTGGATTCTGCCAGTAGTCATATGCTTGTCTCAAAGATTAAGCCATGCATGTCTAAGTATAAGCAATCTATACAGTGAAACTGCGAATGGCTCATTAAATCAGTTATCGTTTATTTGATAGTACCTTACTACTTGGATAACCGTGGTAATTCTAGAGCTAATACATGCTAAAAACCCCGACTTCGGAAGGGGTGTATTTATTAGATAAAAAACCAATGCTCTTCGGGGCTCCTTGGTGATTCATAATAACTTAACGAATCGCATGGCCTTGTGCCGGCGATGGTTCATTCAAATTTCTGCCCTATCAACTTTCGATGGTAGGATAGTGGCCTACCATGGTTTCAACGGGTAACGGGGAATTAGGGTTCTATTCCGGAGAGGGAGCCTGAGAAACGGCTACCACATCCAAGGAAGGCAGCAGGCGCGCAAATTACCCAATCCCGACACGGGGAGGTAGTGACAATAAATACTGATACAGGGCTCTTTTGAGTCTTGTAATTGGAATGAGTACAATTTAAATCCCTTAACGAGGAACAATTGGAGGGCAAGTCTGGTGCCAGCAGCCGCGGTAATTCCAGCTCCAATAGCGTATATTAAAGTTGTTGCAGTTAAAAAGCTCGTAGTTGAACCTTGGGCCTGGCTGGCCGGTCCGCCTCACCGCGTGCACTGGTCCGGCCGGGCCTTTCCTCCTGGGGAGCCGCATGCCCTTCACTGGGTGTGTCGGGGAACCAGGACTTTTACTTTGAAAAAATTAGAGTGTTCAAAGCAGGCCTATGCTCGAATACATTAGCATGGAATAATAGAATAGGACGTGTGGTTCTATTTTGTTGGTTTCTAGGACCGCCGTAATGATTAATAGGGATAGTCGGGGGCATCAGTATTCAATTGTCAGAGGTGAAATTCTTGGATTTATTGAAGACTAACTACTGCGAAAGCATTTGCCAAGGATGTTTTCATTAATCAGTGAACGAAAGTTAGGGGATCGAAGACGATCAGATACCGTCGTAGTCTTAACCATAAACTATGCCGACTAGGGATCGGGCGATGTTATCTTTTTGACTCGCTCGGCACCTTACGAGAAATCAAAGTTTTTGGGTTCTGGGGGGAGTATGGTCGCAAGGCTGAAACTTAAAGAAATTGACGGAAGGGCACCACCAGGAGTGGAGCCTGCGGCTTAATTTGACTCAACACGGGGAAACTCACCAGGTCCAGACACAATAAGGATTGACAGATTGAGAGCTCTTTCTTGATTTTGTGGGTGGTGGTGCATGGCCGTTCTTAGTTGGTGGAGTGATTTGTCTGCTTAATTGCGATAACGAACGAGACCTTAACCTGCTAAATAGCCCGGCTAGCTTTGGCTGGTCGCTGGCTTCTTAGAGGGACTATCGGCTCAAGCCGATGGAAGTTTGAGGCAATAACAGGTCTGTGATGCCCTTAGATGTTCTGGGCCGCACGCGCGCTACACTGACAGAGCCAACGAGTTCATCACCTTGGCCGAAAGGTCTGGGTAATCTTGTTAAACTCTGTCGTGCTGGGGATAGAGCATTGCAATTATTGCTCTTCAACGAGGAATTCCTAGTAGGCGCGAGTCATCAGCTCGTGCCGACTACGTCCCTGCCCTTTGTACACACCGCCCGTCGCTACTACCGATTGAACGGCTAAGTGAGGCTTCCGGACTGGCTCAGGGAGGTCGGCAACGACCACCCAGAGCTGGAAAGTTGTCCAAACTTGGTCGTTTAGAGGAAGTAAAAGTCGTA |
IMAGES: